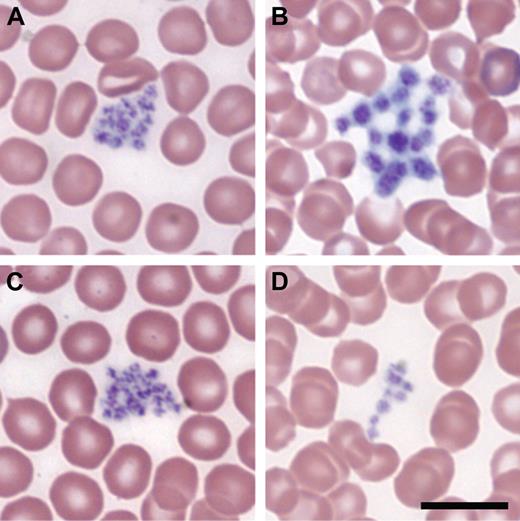
Figure 6. Blood smears showing transgenic rescue of thrombocytopenia. (A) A/J +/+ +/+ with normal-sized platelets, (B) A/J-trac/trac +/+ with enlarged platelets, (C) A/J +/+ Tg (ABCG5/8) with normal-sized platelets, and (D) A/J-trac/trac Tg (ABCG5/8) with normal-sized platelets. Bar represents 10 μm.

Abstract
The spontaneous mouse mutation “thrombocytopenia and cardiomyopathy” (trac) causes macrothrombocytopenia, prolonged bleeding times, anemia, leukopenia, infertility, cardiomyopathy, and shortened life span. Homozygotes show a 20-fold decrease in platelet numbers and a 3-fold increase in platelet size with structural alterations and functional impairments in activation and aggregation. Megakaryocytes in trac/trac mice are present in increased numbers, have poorly developed demarcation membrane systems, and have decreased polyploidy. The thrombocytopenia is not intrinsic to defects at the level of hematopoietic progenitor cells but is associated with a microenvironmental abnormality. The trac mutation maps to mouse chromosome 17, syntenic with human chromosome 2p21-22. A G to A mutation in exon 10 of the adenosine triphosphate (ATP)–binding cassette subfamily G, member 5 (Abcg5) gene, alters a tryptophan codon (UGG) to a premature stop codon (UAG). Crosses with mice doubly transgenic for the human ABCG5 and ABCG8 genes rescued platelet counts and volumes. ABCG5 and ABCG8 form a functional complex that limits dietary phytosterol accumulation. Phytosterolemia in trac/trac mice confirmed a functional defect in the ABCG5/ABCG8 transport system. The trac mutation provides a new clinically significant animal model for human phytosterolemia and provides a new means for studying the role of phytosterols in hematologic diseases and testing therapeutic interventions.
Introduction
Basic mechanisms that underlie platelet production have been elucidated through clinical studies of heritable thrombocytopenia in humans and by investigations of genetically determined platelet disorders in experimental animals. Thrombocytopenia can result from decreased platelet production, production of abnormal platelets, increased destruction, loss as a consequence of hemorrhage, and platelet sequestration.1 Clinical familial entities that manifest a defect in platelet production or function include more than 100 listings in Online Mendelian Inheritance in Man (OMIM).2
Mice bearing spontaneous and genetically engineered mutations have been studied extensively as models for many familial human hematologic and immunologic diseases.3-5 These mutant mice provide valuable tools to clarify basic physiologic processes and serve as models for experimental interventions that may lead to new treatments. A new spontaneous mutation “thrombocytopenia and cardiomyopathy” (trac) occurred in 1987 in the Animal Resources colony of A/J mice at The Jackson Laboratory. Affected animals were small and had shortened life spans. Pathologic and hematologic studies of trac/trac mice revealed severe macrothrombocytopenia accompanied by cardiomyopathy and infertility. In this first report of the trac mutation we describe the thrombocytopenia and other hematologic defects, determine the chromosomal location of the trac locus, identify the molecular basis of the mutation as a model for human hereditary sitosterolemia/phytosterolemia, and document greatly elevated levels of plasma phytosterols. Cardiomyopathy and infertility are the subject of another manuscript (T.H.C. and L.D.S., manuscript in preparation).
Methods
Mice
The trac mutation was studied on the A/J strain background and was also backcrossed 10 generations to the BALB/cBy strain. Identification of BALB/cBy +/trac heterozygotes during backcrossing was based on polymorphisms at the D17Mit2 and D17Mit129 dinucleotide repeat markers that flanked the trac locus. C57BL/6J (B6), A/J, BALB/cBy, B6SJL-Tg(ABCG5/ABCG8)14-2Hobb/J, and B6;129S6-Abcg5/Abcg8Tm1Hobb/J (abbreviated as (Abcg5/Abcg8)−/− mice were obtained from the Animal Resources colony at The Jackson Laboratory. After weaning at 3 weeks, all mice were reared on Purina 5K52 diet (6% fat) and acidified water ad libitum. All experimental protocols were approved by The Jackson Laboratory Institutional Animal Care and Use Committee, and are in accordance with accepted institutional and governmental policies.
Ovarian transplants
Ovaries from A/J-trac/trac females were transplanted to histocompatible (A/J) or immunodeficient (C3H/JeJ-Prkdcscid/Prkdcscid) hosts followed by mating to A/J +/+ males. The +/trac offspring were then sib-mated. The mutant and control mice were produced from matings between heterozygotes. Two-thirds of the control mice were expected to be +/trac and one-third, +/+. Control mice of the 2 phenotypes are phenotypically indistinguishable and will be referred to as +/? controls.
Transgenic rescue
B6SJL-Tg(ABCG5/ABCG8) males were crossed with BALB/cBy +/trac females. F1 offspring genotyped as heterozygous for the trac mutation and hemizygous for the linked (ABCG5/ABCG8) transgenes were crossed with A/J +/trac nontransgenic mice. This cross resulted in trac/trac Tg(ABCG5/ABCG8) mice, trac/trac nontransgenic mice, as well as transgenic and nontransgenic +/trac and +/+ controls.
Life span determination
Data for life span determination were collected from ages of mice at time of death or age at date of killing for mice that were humanely killed when moribund.
Hematologic measurements
For blood counts and preparation of smears, mice were bled from the retro-orbital sinus with ethylenediaminetetraacetic acid–coated 75-mm capillary tubes (Drummond Scientific). Blood smears were air dried, fixed in methanol, and stained with Wright stain. Complete blood counts,6 red blood cell (RBC) fragility,7 and bleeding times8 were measured as previously described. In cases where bleeding did not stop spontaneously at 5 minutes, it was stopped by application of pressure and bleeding time was recorded as 5 minutes. Platelet activation measured by up-regulation of integrin αIIb β3 (glycoprotein IIb/IIIa, CD41/CD61) was done by flow cytometry using JON/A antibody (Emfret Analytics).9 Platelet aggregation measurements using bovine collagen as the agonist were performed by impedance-based whole blood in a Chrono-Log Model 700 aggregometer as described.10 Results were reported as area under the curve.
Histologic examination
After CO2 asphyxiation, necropsies were carried out and tissues harvested from more than 25 trac/trac and +/− control mice at 6 to 17 weeks of age. Tissues were fixed in Bouin solution (LabChem), embedded in paraffin, and sectioned at 5 μm. Tissue sections stained with Mayer hematoxylin and eosin (H&E), or Masson trichrome, were visualized on an Olympus CX41 equipped with a Leica DFC420 digital color camera. Low-power images were scanned with a PathScan Enabler IV (Meyer Instruments; Figure 2A-B), or a Leica DMRXE wide-field microscope (Leica Microsystems) using a PlanApo 100×/1.4 oil objective or a PlanApo 40×/.75 dry objective. Digital images were captured with a Leica DFC300FX camera (Figure 2C-K). Color-subtractive computer-assisted image analysis with ImageJ software (National Institutes of Health [NIH]) of Masson trichrome–stained sections was used as described to quantify percentage of collagen.11
To enumerate megakaryocytes in H&E-stained sections of spleen, 3 hot spot areas containing high concentrations of megakaryocytes were identified in the red pulp by visually scanning the entire section of each tissue sample. Megakaryocytes were identified by their large size and characteristic large lobulated basophilic nuclei and abundant cytoplasm.12 A graticule with 16 squares of 0.25 mm × 0.25 mm was oriented over each hot spot and all megakaryocytes within the grid area were counted at ×200 magnification. The mean number of megakaryocyte counts for each splenic section was calculated by averaging the 3 hot spot counts.
Flow cytometric analyses of megakaryocyte numbers and ploidy
Bone marrow (BM) and spleen cell suspensions were prepared as previously described.13 Flow cytometric analyses used a Becton Dickinson FACScan equipped with 5-color upgrade by Cytek Development using monoclonal antibodies obtained from BD Pharmingen. Megakaryocytes were identified based on coexpression of CD41 (integrin α2b) and CD61 (integrin β3). Ploidy was determined as previously described.14
Immunofluorescence microscopy
Immunofluorescence microscopic analysis of megakaryocytes and analysis of β1-tubulin expression were carried out as described previously.15 For analysis of platelets, rabbit polyclonal anti–β1-tubulin antibody was a gift of Nick Cowan, New York University. Anti–rabbit secondary antibody was conjugated to Alexa Fluor 488 (Molecular Probes). Platelets were viewed with a Nikon Eclipse TE-2000E microscope using 60× or 100× (NA 1.4) differential interference contrast objectives with a 1.5× optivar. Images were captured with an Orca-II ER cooled CCD camera (Hamamatsu) equipped with an electronic shutter. Shutter and image acquisition were controlled by Metamorph software (Universal Imaging Corporation; Molecular Devices). The diameters of the platelet β1-tubulin coils were measured using the Metamorph software calipers tool.
For analysis of megakaryocytes, rabbit SuperGlu antidetyrosinated tubulin antibody that was a gift from Dr J. Chloe Bulinski (Columbia University, New York, NY) was used at 1:500 dilution. Images were obtained using a Zeiss Axiovert 200 equipped with a 60× differential interference contrast oil-immersion objective.
Transmission electron microscopy
Transmission electron microscopy (TEM) on blood collected from the retro-orbital plexus, bone marrow, and spleen was performed as previously described.6
Colony assay for CFU-MK
Numbers of megakaryocyte colony-forming units (CFU-MK) in BM cell suspensions were enumerated using a MegaCult-C kit (StemCell Technologies) formulated for mouse CFU-MKs. Cultures were carried out following the manufacturer's protocol. Cytokine combination used included 50 ng/mL recombinant human thrombopoietin, 10 ng/mL recombinant murine interleukin-3 (IL-3), 20 ng/mL recombinant human IL-6, and 50 ng/mL recombinant human IL-11.
Genetic mapping of the trac locus
A/J-trac/trac ovary recipient females were mated with C57BL/6 males. The (A/J × C57BL/6) F1 +/trac offspring were intercrossed. In the F2 generation, identification of affected homozygous trac/trac mice was based on a thin and debilitated appearance and confirmed by histologic evidence of cardiomyopathy and by hematologic evidence of thrombocytopenia. Linkage testing was carried out using dinucleotide repeat polymorphisms (MIT markers) typed by polymerase chain reaction (PCR) amplification. PCR analyses were carried out in 10-μL reactions containing 20 ng of genomic DNA. A DNA pooling strategy facilitated a genome-wide linkage screen. Gene order and recombination frequencies were calculated with the Map Manager computer program, a Macintosh program for storage and analysis of experimental mapping data. For high-resolution mapping, the website http://danio.mgh.harvard.edu/mouseMarkers/musssr.html16 was used to locate additional simple sequence repeats that differed between the A/J and BL/6 strains. The website was also used to generate DNA sequences of PCR primer pairs for amplification of the new simple sequence repeats.
DNA sequencing and identification of the trac mutation
Primers for amplification of candidate gene cDNAs were designed using Primer3 (http://frodo.wi.mit.edu/primer3).17 Amplified DNA products were treated with ExoSAP-IT (USB Corporation) and sequenced using BigDye Terminators Kit Version 3.1 (Applied Biosystems [ABI]). The subsequent sequencing reactions were cleaned up using ABI's XTerminator solution (ABI) and then run on an ABI 3730xl DNA Analyzer. Sequencing data were analyzed using ABI's Sequencing Analysis software. Sequences were assembled using Sequencher 4.2 (Gene Codes Inc). DNA from mutant mice was analyzed and compared with controls. A 223-bp product containing the G>A mutation was amplified from alkaline lysis–generated genomic DNA. The primers used were forward primer tracF, GTCGAGTTCAGCCTGGGTAG and reverse primer tracR, GGACACCGCCTTACCAATAA. The product was treated with ExoSAP-IT (USB Corporation) and sequenced to determine the genotype.
Quantitation of plasma sterol levels
Plasma (ethylenediaminetetraacetic acid anticoagulant) was collected for quantification of phytosterol and cholesterol levels. A novel analytic platform based on liquid chromatography/tandem mass spectrometry using atmospheric pressure photoionization enabled the simultaneous quantification of free and esterified β-sitosterol, campesterol, brassicasterol, stigmasterol, and cholesterol.18 Stock solutions of all phytosterols and cholesterol were prepared in isopropanol.
Development of megakaryocytes from fetal liver cells
Mouse megakaryocytes were cultured as described19 then resuspended in Dulbecco modified Eagle medium with 10% fetal bovine serum albumin, 50 U/mL penicillin, 50 μg/mL streptomycin, and 0.1 μg/mL purified recombinant human c-Mpl ligand alone, and in the presence of 5% serum from trac/trac or +/trac mice, and cultured at 37°C before analysis on day 5.
Statistical analyses
Data were expressed as the mean value plus or minus the SE. Significant differences between data groups were determined by 2-sample Student t test analysis. A P value less than .05 was considered significant.
Results
Occurrence of the trac mutation
The trac mutation occurred spontaneously in the A/J inbred strain at The Jackson Laboratory. Affected mice were first identified by their small size and hunched appearance by 12 weeks followed by progressive decline and death by 4 to 6 months of age. Determination of the cause of death as cardiomyopathy, and the presence of thrombocytopenia, led to the naming of the mutation as “thrombocytopenia and cardiomyopathy,” with the gene symbol trac. Preliminary breeding experiments revealed that both males and females were infertile. Male infertility was associated with defective spermatogenesis. Transfer of ovaries from trac/trac females to ovarectomized immunodeficient recipients followed by mating to A/J +/+ males produced +/trac mice.
Intercrossing of +/trac heterozygotes produced 25% affected mice. Thus trac segregated as an autosomal recessive mutation. All homozygous mice developed thrombocytopenia. Thus it is fully penetrant on the A/J strain background. A/J-trac/trac homozygotes have a mean life span of 139.8 plus or minus 9.9 days (Figure 1A). There was no effect of sex on life span. A/J +/trac breeders survived to at least 8 months, at which time they were killed. There was no effect of heterozygosity at the trac locus on platelet numbers or platelet volumes in young (2-3 months) or aged (6-8 months) A/J +/trac mice (data not shown).
Quantitative abnormalities of A/J-trac/trac mice. (A) Survival data showing the short life span of A/J-trac/trac mice. There was no significant difference in life span of males and females (n = 18). (B-C) Platelet numbers and platelet volumes in A/J-trac/trac and +/? sex-matched littermate mice. Each bar represents the mean and SE from 4 to 9 mice analyzed at 10 to 17 weeks of age. (B) Platelet numbers showing severely reduced counts in A/J-trac/trac mice. (C) Platelet volumes showing markedly increased volumes in A/J-trac/trac mice. (D) Bleeding times were prolonged in A/J-trac/trac mice; n = 5 pairs of 6- to 12-week-old A/J-trac/trac and control mice. (E) Platelet activation was impaired in A/J-trac/trac mice at 3 to 4 weeks of age (n = 4). (F) In 3-week-old A/J-trac/trac mice, platelet aggregation was not significantly different from controls, but by 11 weeks of age they had greatly reduced platelet aggregation performance as measured by the whole blood impedance method. Data show area under the curve using the whole blood impedance method. (G) RBC fragility graph showing increased fragility of A/J-trac/trac RBCs (*P < .05; **P < .01; ***P < .001).
Quantitative abnormalities of A/J-trac/trac mice. (A) Survival data showing the short life span of A/J-trac/trac mice. There was no significant difference in life span of males and females (n = 18). (B-C) Platelet numbers and platelet volumes in A/J-trac/trac and +/? sex-matched littermate mice. Each bar represents the mean and SE from 4 to 9 mice analyzed at 10 to 17 weeks of age. (B) Platelet numbers showing severely reduced counts in A/J-trac/trac mice. (C) Platelet volumes showing markedly increased volumes in A/J-trac/trac mice. (D) Bleeding times were prolonged in A/J-trac/trac mice; n = 5 pairs of 6- to 12-week-old A/J-trac/trac and control mice. (E) Platelet activation was impaired in A/J-trac/trac mice at 3 to 4 weeks of age (n = 4). (F) In 3-week-old A/J-trac/trac mice, platelet aggregation was not significantly different from controls, but by 11 weeks of age they had greatly reduced platelet aggregation performance as measured by the whole blood impedance method. Data show area under the curve using the whole blood impedance method. (G) RBC fragility graph showing increased fragility of A/J-trac/trac RBCs (*P < .05; **P < .01; ***P < .001).
Effect of the trac mutation on peripheral blood counts and bleeding time
Analyses of peripheral blood of A/J-trac/trac and sex-matched +/? control mice at 10 to 17 weeks of age showed a 20-fold reduction in platelet numbers (61.11 ± 5.7 × 109/L for trac/trac mice vs 1284 ± 37.1 × 109/L for littermate controls) accompanied by a 3-fold increased platelet volume (16 ± 1 fL for trac/trac mice versus 5 ± .1 fL for littermate controls; Figure 1B-C). There was no significant effect of sex on platelet numbers or volumes in either A/J-trac/trac or +/? mice.
The functional effect of the thrombocytopenia was confirmed by greatly increased bleeding times following amputation of the tail tip (Figure 1D). Bleeding times for +/? littermate control mice were 78.2 plus or minus 9.9 seconds, compared with bleeding times in excess of 300 seconds for trac/trac mice. Functional testing of platelet activation and aggregation revealed decreased platelet activation response in A/J-trac/trac mice (Figure 1E), as well as the development of impaired platelet aggregation by 11 weeks of age (Figure 1F).
Young adult A/J-trac/trac mice also had mild regenerative hemolytic anemia (hematocrit [Hct] = 36.2% ± 0.9% for trac/trac vs 45.3% ± 1.4% for littermate controls), which was accompanied by a doubling in numbers of reticulocytes (5.9% ± 0.3% for trac/trac mice vs 2.8% ± 0.2% for littermate controls). Further testing revealed increased RBC fragility in trac/trac mice (Figure 1E). A/J-trac/trac mice showed a 2-fold reduction in the numbers of white blood cells compared with littermate controls, with an increased percentage of neutrophils and decreased percentages of lymphocytes (Table 1).
Postmortem examination
Postmortem examination showed marked cardiomyopathy with multifocal myocardial fibrosis (Figure 2A-C). Color-subtractive computer-assisted image analysis showed a 7-fold increase in collagen deposition in the myocardium of adult trac/trac mice compared with age-matched controls (Figure 2B). There was also spermatic abiotrophy as evidenced by the presence of sperm in testicular tubules and only a few degenerate sperm in the epididymis (not shown). These findings are the subjects of manuscripts in preparation (T.H.C. and L.D.S., manuscript in preparation).
Histopathologic and hematologic abnormalities of A/J-trac/trac mice. (A) Heart and myocardium (inset) of A/J +/? control mouse showing normal structure, higher magnification insets of boxed areas. (B) Determination of collagen deposition in heart ventricles by color-subtractive computer-assisted image analysis showed a mean of 1.9% collagen in A/J +/? controls and 14.6% in A/J-trac/trac mice, a 7-fold increase in collagen deposition (n = 5). (C) Heart and myocardium (inset) of A/J-trac/trac mouse showing cardiomyopathy with severe multifocal fibrosis. (D-L) Peripheral blood smears and histopathology of BM, spleen, and lungs. (D-F) Blood smears of A/J-trac/trac and +/? control mice at 10 weeks of age. (D) A/J +/? mouse blood smear showing normal platelet size. (E) A/J-trac/trac blood smear showing greatly enlarged platelets. (F) A/J-trac/trac blood smear showing megakaryocyte. (G-H) Vertebral BM at 15 weeks. (G) A/J +/? BM showing normal distribution of megakaryocytes. (H) A/J-trac/trac BM showing increased numbers of megakaryocytes. (I-J) Red pulp of spleen. (I) A/J +/? spleen showing normal distribution of megakaryocytes. (J) A/J-trac/trac spleen showing increased numbers of megakaryocytes. (K-L) Lungs. (K) A/J +/? lungs showing normal structure. (L) A/J-trac/trac lungs showing megakaryocytes in alveolar capillary bed (arrows). (A,C) Masson trichrome stain; bars represent 1 mm. (D-F) Wright stain. (G-L) Hematoxylin and eosin; bars represent 10 μm.
Histopathologic and hematologic abnormalities of A/J-trac/trac mice. (A) Heart and myocardium (inset) of A/J +/? control mouse showing normal structure, higher magnification insets of boxed areas. (B) Determination of collagen deposition in heart ventricles by color-subtractive computer-assisted image analysis showed a mean of 1.9% collagen in A/J +/? controls and 14.6% in A/J-trac/trac mice, a 7-fold increase in collagen deposition (n = 5). (C) Heart and myocardium (inset) of A/J-trac/trac mouse showing cardiomyopathy with severe multifocal fibrosis. (D-L) Peripheral blood smears and histopathology of BM, spleen, and lungs. (D-F) Blood smears of A/J-trac/trac and +/? control mice at 10 weeks of age. (D) A/J +/? mouse blood smear showing normal platelet size. (E) A/J-trac/trac blood smear showing greatly enlarged platelets. (F) A/J-trac/trac blood smear showing megakaryocyte. (G-H) Vertebral BM at 15 weeks. (G) A/J +/? BM showing normal distribution of megakaryocytes. (H) A/J-trac/trac BM showing increased numbers of megakaryocytes. (I-J) Red pulp of spleen. (I) A/J +/? spleen showing normal distribution of megakaryocytes. (J) A/J-trac/trac spleen showing increased numbers of megakaryocytes. (K-L) Lungs. (K) A/J +/? lungs showing normal structure. (L) A/J-trac/trac lungs showing megakaryocytes in alveolar capillary bed (arrows). (A,C) Masson trichrome stain; bars represent 1 mm. (D-F) Wright stain. (G-L) Hematoxylin and eosin; bars represent 10 μm.
Histologic examination of blood smears
Examination of peripheral blood smears from A/J-trac/trac mice at 6 to 10 weeks of age revealed anisocytosis, the presence of stomatocytes, greatly enlarged platelets (Figure 2D-E), and occasional megakaryocytes (Figure 2F). There was no evidence of the inclusions, as has been reported in granulocytes of patients with May-Hegglin anomaly and other giant platelet syndromes20 either by light or electron microscopy (data not shown).
Further characterization of megakaryocytes and their distribution
Examination of H&E–stained tissue sections showed increased numbers of megakaryocytes in BM (Figure 2G-H), spleen (Figure 2I-J), and lungs (Figure 2K-L) of trac/trac mice. Flow cytometric analyses of BM cells from 3 pairs of 4- to 8-week-old trac/trac and +/? mice showed a 4-fold increase in percentages of CD41+CD61+ double-positive megakaryocytes in trac/trac (4.3% ± 4.4%) versus +/? (1.1% ± 0.3%) mice (P < .05).
Determination of splenic megakaryocyte counts by morphologic criteria in 5 pairs of trac/trac and littermate +/? mice at 10 to 15 weeks of age revealed 17.2 plus or minus 6.33 megakaryocytes per field in trac/trac mice versus 6.3 plus or minus 0.64 for +/? controls (P < .001), a 2.7-fold increase in the number of megakaryocytes in the spleens of trac/trac mice. Flow cytometry on spleen cells showed a 5-fold increase in CD41+CD61+ megakaryocytes in trac/trac mice (4.2% ± 4.2% for trac/trac mice vs 0.8% ± 0.70% for controls; P < .05).
As part of their normal maturation process, megakaryocytes undergo endomitosis 3 to 4 times, resulting in degrees of polyploidy of 16 to 32N. Megakaryocyte ploidy analysis showed that in A/J +/+ control mice there were 3 to 4 endomitoses, resulting in most megakaryocytes being 16N or greater in both BM and spleen, whereas the BM and spleen megakaryocytes of A/J-trac/trac mice most commonly underwent only one endomitosis to 4N (Table 2).
β1-Tubulin expression
One of the most prominent features of the resting platelet ultrastructure is a coil of microtubules that defines the periphery of the platelet.21,22 The increase in size of the trac/trac platelets suggested that these microtubule coils may be altered. Examination of β1-tubulin–stained platelets revealed more intense staining and a 1.5-fold increase in the diameter of the microtubule coils of 36-day-old female A/J-trac/trac mice, 4.3 plus or minus 0.13 nm versus 2.9 plus or minus 0.09 nm for age- and sex-matched +/? control platelets (Figure 3A-B).
Immunofluorescent and transmission electron microscopic changes in platelets and megakaryocytes. (A-B) Immunofluorescence photomicrographs of platelets stained with anti–β1-tubulin antibody at 1000 ×; bars represent 5 μM. (A) A/J +/? control platelets showing normal β1-tubulin immunoreactivity. (B) Enlarged A/J-trac/trac platelets showing increased β1-tubulin immunoreactivity. (C-F) TEM of platelets and megakaryocytes. (C) A/J +/+ platelet showing normal structure. (D) A/J-trac/trac platelet showing large size, numerous small alpha granules, and increased numbers of mitochondria in each platelet. (E) A/J +/+ megakaryocyte showing well-developed platelet demarcation membrane system (DMS). (F) A/J-trac/trac megakaryocyte showing altered DMS. (C-F) Bars represent 500 nM.
Immunofluorescent and transmission electron microscopic changes in platelets and megakaryocytes. (A-B) Immunofluorescence photomicrographs of platelets stained with anti–β1-tubulin antibody at 1000 ×; bars represent 5 μM. (A) A/J +/? control platelets showing normal β1-tubulin immunoreactivity. (B) Enlarged A/J-trac/trac platelets showing increased β1-tubulin immunoreactivity. (C-F) TEM of platelets and megakaryocytes. (C) A/J +/+ platelet showing normal structure. (D) A/J-trac/trac platelet showing large size, numerous small alpha granules, and increased numbers of mitochondria in each platelet. (E) A/J +/+ megakaryocyte showing well-developed platelet demarcation membrane system (DMS). (F) A/J-trac/trac megakaryocyte showing altered DMS. (C-F) Bars represent 500 nM.
Ultrastructural examination of platelets and megakaryocytes
TEM examination of blood from A/J-trac/trac mice revealed greatly enlarged spherical platelets containing increased numbers (per platelet) of small, immature α-granules, increased numbers of mitochondria, and scattered remnants of rough endoplasmic reticulum normally lost during platelet maturation, and lacking normal microtubular elements (Figure 3C-D).
Megakaryocytes from trac/trac mice showed absence of a well-defined demarcation membrane system (DMS). Instead of the normal organization of the membranes of the DMS into sheets, there was a change to a spherical or bubblelike appearance. In addition, the endoplasmic reticulum of trac/trac megakaryocytes was more prominent and dilated, and there were fewer α-granules, fewer dense bodies, and a wider peripheral zone (not shown; Figure 3E-F).
Platelet numbers and volumes in trac/trac mice are normal at weaning
Hematologic analyses at weaning (18-21 days of age) of litters born from A/J +/trac breeders revealed normal platelet counts and volumes. However, within a few weeks after weaning, hematologic analyses of A/J-trac/trac mice showed a precipitous drop in platelet counts (Figure 4A) and marked increase in platelet volumes (Figure 4B).
Change in platelet numbers and volumes of A/J-trac/trac mice after weaning. (A) Platelet numbers showing a marked decline in A/J-trac/trac platelet numbers at 3 to 5 weeks of age. (B) Platelet volumes showing a marked increase in A/J-trac/trac platelet volumes at 3 to 5 weeks of age.
Change in platelet numbers and volumes of A/J-trac/trac mice after weaning. (A) Platelet numbers showing a marked decline in A/J-trac/trac platelet numbers at 3 to 5 weeks of age. (B) Platelet volumes showing a marked increase in A/J-trac/trac platelet volumes at 3 to 5 weeks of age.
Numbers of megakaryocyte progenitors are increased 2-fold in trac/trac bone marrow
To quantify numbers of megakaryocyte progenitors, colony assays were carried out in BM from 5 pairs of A/J-trac/trac and +/? mice at 19 to 34 weeks of age. Numbers of colonies per culture dish were 23.4 plus or minus 1.50 for A/J-trac/trac mice versus 12.2 plus or minus 1.30 for +/− controls (P = .002).
High-resolution mapping of the trac locus
Genetic crosses were carried out to determine the chromosomal location of the trac mutation. Recipients of A/J-trac/trac ovaries were first mated with C57BL/6J (B6) +/+ males. Intercrossing of male and female (A/J × B6) F1 +/trac heterozygotes produced 1102 F2 progeny. Identification of 277 trac/trac homozygotes (25.14%) was based on the presence of thrombocytopenia. The flanking MIT markers D17Mit155 at 84.4 Mb and D17Mit76 at 85.5 Mb narrowed the interval to 1.1 Mb, which included 17 genes. Custom primer sets were then designed to genotype 3 additional simple sequence repeat markers that narrowed the interval to 0.3 Mb, which contained only 4 genes: dynein 2 light intermediate chain (D2lic); adenosine triphosphate (ATP)–binding cassette, subfamily G (WHITE), member 5 (Abcg5); ATP-binding cassette, subfamily G (WHITE), member 8 (Abcg8); and leucine-rich PPR-motif containing (Lrpprc).
Sequencing of candidate genes and identification of Abcg5 as the disrupted gene
Sequencing of the cDNA from the 4 genes within the interval revealed a G to A mutation at base 1435 of Abcg5 (reference sequence NM_031884.1; Figure 5A-B). No DNA alterations were found in any of the other candidate genes within the interval. The G to A base substitution changes a tryptophan to a premature stop codon (UGG to UAG). The transmembrane helices prediction program TMHMM Version 2.0 (http://www.cbs.dtu.dk/services/TMHMM)24 predicts that the premature stop codon would result in a mutant protein that lacks the last 4 transmembrane domains of the wild-type protein (Figure 5C black box).
Genomic structure of the Abcg5 and Abcg8 genes showing the site and nature of the trac mutation. (A) Abcg5 and Abcg8 are arranged tandemly head to head in opposite transcriptional orientations (arrows) and span ∼ 42 kb on mouse chromosome 17 from position 84.567 Mb to 84.609 Mb (National Center for Biotechnology Information build 36)23 as shown in the scale at the top of the figure. Individual exons of each gene are numbered and represented as filled rectangles and introns are represented as connecting lines. (B) The trac mutation is a G to A base pair substitution in exon 10 of the Abcg5 gene. The mutation changes a UGG tryptophan (Trp) codon in wild-type (+/+) mice to a UGA stop codon in mutant (trac/trac) mice. (C) The normal mouse ABCG5 protein (NP_114090) is composed of 652 amino acids and contains 6 predicted transmembrane domains (gray cylinders). The premature stop codon introduced by the trac mutation at amino acid position 462 is predicted to truncate the protein after the second transmembrane domain and eliminate 190 amino acids containing 4 additional transmembrane domains (region enclosed in black box).
Genomic structure of the Abcg5 and Abcg8 genes showing the site and nature of the trac mutation. (A) Abcg5 and Abcg8 are arranged tandemly head to head in opposite transcriptional orientations (arrows) and span ∼ 42 kb on mouse chromosome 17 from position 84.567 Mb to 84.609 Mb (National Center for Biotechnology Information build 36)23 as shown in the scale at the top of the figure. Individual exons of each gene are numbered and represented as filled rectangles and introns are represented as connecting lines. (B) The trac mutation is a G to A base pair substitution in exon 10 of the Abcg5 gene. The mutation changes a UGG tryptophan (Trp) codon in wild-type (+/+) mice to a UGA stop codon in mutant (trac/trac) mice. (C) The normal mouse ABCG5 protein (NP_114090) is composed of 652 amino acids and contains 6 predicted transmembrane domains (gray cylinders). The premature stop codon introduced by the trac mutation at amino acid position 462 is predicted to truncate the protein after the second transmembrane domain and eliminate 190 amino acids containing 4 additional transmembrane domains (region enclosed in black box).
Transgenic rescue of thrombocytopenia
To determine whether expression of a normal ABCG5 transgene could rescue thrombocytopenia in trac/trac mice, crosses between mice doubly transgenic for the tightly linked human ABCG5 and ABCG8 genes and +/trac heterozygotes were carried out. These crosses produced mice that were transgenic for the ABCG5 and ABCG8 genes (referred to as (ABCG5/ABCG8) and homozygous for the trac mutation along with nontransgenic trac/trac mice and transgenic control (+/trac or +/+ ABCG5/ABCG8) animals. The transgenic mice are maintained on a segregating B6SJL strain background and have approximately 10 copies of the human ABCG5 and ABCG8 genes under the direction of their endogenous regulatory sequences.25 For genetic crosses with the transgenic mice, we used a stock of BALB/cBy-trac mice created by crossing the trac mutation for 10 generations from the A/J strain onto the BALB/cBy strain background. As shown in Table 3 and Figure 6, homozygous mutant (BALB/cBy × B6SJL)-trac/trac mice that also inherited the ABCG5 and ABCG8 transgenes have normal platelet counts and platelet volumes, whereas the nontransgenic (BALB/cBy × B6SJL)-trac/trac mice, as expected, showed severe macrothrombocytopenia.
Blood smears showing transgenic rescue of thrombocytopenia. (A) A/J +/+ +/+ with normal-sized platelets, (B) A/J-trac/trac +/+ with enlarged platelets, (C) A/J +/+ Tg (ABCG5/8) with normal-sized platelets, and (D) A/J-trac/trac Tg (ABCG5/8) with normal-sized platelets. Bar represents 10 μm.
Blood smears showing transgenic rescue of thrombocytopenia. (A) A/J +/+ +/+ with normal-sized platelets, (B) A/J-trac/trac +/+ with enlarged platelets, (C) A/J +/+ Tg (ABCG5/8) with normal-sized platelets, and (D) A/J-trac/trac Tg (ABCG5/8) with normal-sized platelets. Bar represents 10 μm.
Mice homozygous for the Abcg5/Abcg8 targeted mutations develop macrothrombocytopenia
Previous reports on Abcg5/Abcg8 double knockout mice maintained on a segregating strain background did not include examination of platelet levels.26-28 Examination of platelet counts and volumes from 4 pairs of B6;129-(Abcg5/Abcg8)−/− and littermate control (Abcg5/Abcg8)+/? heterozygous mice at 5 to 7 months of age showed marked macrothrombocytopenia in the (Abcg5/Abcg8)+/? mice (Table 4). There was no significant difference between the (Abcg5/Abcg8)−/− and littermate control (Abcg5/Abcg8)+/? heterozygotes in either RBC or leukocyte counts (data not shown).
Effect of the trac mutation on plasma phytosterol levels
ABCG5 and ABCG8 are obligate hemitransporters and form a functional complex that limits the accumulation of dietary phytosterols,29,30 which are common components of plant foods especially vegetable oils, seeds, nuts, and cereals.18 They are structurally similar to cholesterol, differing only in the number of carbons and/or double bonds in the side chains.18 Mutations in either the ABCG5 or ABCG8 genes result in phytosterolemia, a rare inherited condition characterized by increased levels of plasma and tissue plant sterols due to higher intestinal absorption and impaired biliary secretion of phytosterols.31
Disruption of the Abcg5 gene by the trac mutation predicts elevated levels of sitosterol and other phytosterols in the plasma of trac/trac mice. As shown in Table 5, A/J-trac/trac plasma showed an approximately 130-fold and approximately 60-fold increase in free and esterified sitosterol, respectively, compared with A/J +/? control mice. Plasma levels of other plant sterols including free and esterified stigmasterol, brassicasterol, and campesterol were also significantly elevated. There was no effect of the trac mutation on levels of free cholesterol. However, levels of esterified cholesterol were decreased to approximately one-half those found in plasma from littermate normal +/? controls.
A/J-trac/trac phytosterol-rich serum interferes with development of megakaryocytes in normal fetal liver cell cultures
Megakaryocytes generate platelets by remodeling their cytoplasm into long proplatelet extensions, which serve as assembly lines for platelet production.15 To test the hypothesis that the presence of heightened phytosterol levels interferes with normal development of megakaryocytes and production of proplatelets, normal fetal mouse liver megakaryocytes were cultured in the presence of A/J-trac/trac or +/? serum. The finding that the microenvironmental defect resulting in thrombocytopenia was associated with greatly elevated serum phytosterol levels suggests that addition of trac/trac serum into normal fetal liver megakaryocyte cultures would result in abnormal proplatelet production. When fetal liver megakaryocytes from embryonic day 13 CD1 mouse fetuses were cultured in the presence of serum (5%) obtained from adult phytosterolemic A/J-trac/trac mice, there was a 63% reduction in the number of proplatelet-producing megakaryocytes: 26% plus or minus 4.2% in the presences of A/J-trac/trac serum versus 71% plus or minus 7.2% in A/J +/? control serum (Figure 7).
Generation of proplatelets from normal mouse fetal liver cultures. (A) Appearance of normal fetal liver megakaryocytes generating normal proplatelet processes when cultured with 5% A/J +/+ sera. (B) Appearance of normal fetal liver megakaryocytes cultured with 5% A/J-trac/trac sera failing to generate proplatelet processes. Representative samples were stained with rabbit polyclonal antibody SUP GLU, diluted 1:1000, which recognizes detyrosinated tubulin. Bar represents 5 μm. (C) Seventy-one percent of normal fetal liver megakaryocytes generated proplatelet processes when cultured with 5% A/J +/+ sera versus 26% when cultured with 5% A/J-trac/trac sera.
Generation of proplatelets from normal mouse fetal liver cultures. (A) Appearance of normal fetal liver megakaryocytes generating normal proplatelet processes when cultured with 5% A/J +/+ sera. (B) Appearance of normal fetal liver megakaryocytes cultured with 5% A/J-trac/trac sera failing to generate proplatelet processes. Representative samples were stained with rabbit polyclonal antibody SUP GLU, diluted 1:1000, which recognizes detyrosinated tubulin. Bar represents 5 μm. (C) Seventy-one percent of normal fetal liver megakaryocytes generated proplatelet processes when cultured with 5% A/J +/+ sera versus 26% when cultured with 5% A/J-trac/trac sera.
Discussion
In this paper we describe the trac mutation characterized clinically as causing thrombocytopenia and cardiomyopathy. This is the first description of a spontaneous single-gene mouse mutation at the Abcg5 gene resulting in a wide range of pathophysiologic effects that present a clinically significant model for human hereditary phytosterolemia. The most striking hematologic effect of the trac mutation is a 20-fold reduction in platelet numbers accompanied by a 3-fold increased platelet size that occurs rapidly after weaning. TEM revealed that these large platelets lack normal microtubular coils and contain increased numbers of small, immature α-granules, increased numbers of mitochondria in each platelet, and scattered remnants of organelles such as rough endoplasmic reticulum that are normally lost during platelet maturation. Immunofluorescence microscopy showed that the β1-tubulin coils had a 2-fold increase in diameter. Prolonged bleeding times confirmed that there was also a functional defect in hemostasis. Platelet functional testing revealed that these large abnormal platelets have an impaired activation response as determined by flow cytometric assays and by 11 weeks of age lose the ability to aggregate normally as tested in whole blood by the impedance method.
In adult mice platelets are produced by megakaryocytes in the BM and spleen. Flow cytometry and cytologic enumeration showed that the thrombocytopenia in A/J-trac/trac mice was paradoxically associated with increased numbers of splenic and BM megakaryocytes. Normal megakaryocytes undergo endocytosis 3 to 4 times, resulting in polyploidy of 16N to 32N. However, in trac/trac mice megakaryocytes typically undergo only one round of endomitosis, resulting in reduced polyploidy. Megakaryocytes normally generate platelets by remodeling their cytoplasm into long, branched proplatelets, which serve as assembly lines for platelet production. The formation of elongated proplatelet intermediates is normally accompanied by a large increase in total surface area. One of the hallmark features of mature megakaryocytes is a highly invaginated membrane system, called the demarcation membrane system (DMS). The DMS functions to provide a membrane reserve that undergoes evagination during the formation of proplatelets. Thus, the reorganization of this membrane system is crucial for proplatelet extension and platelet production.32,33 Ultrastructurally, these intricate membranes have the appearance of very long narrow parallel membranes. In trac/trac megakaryocytes, there is a poorly developed DMS that appears ultrastructurally as short sections of dilated DMS, often spherical in appearance. In normal megakaryocytes membranous strands wrap β1-tubulin coils and cytoplasmic material to form discoid platelets 2 to 3 micrometers in diameter, containing the granules and other subcellular components of the normal platelet. The defect in trac/trac megakaryocytes results in the production of exceedingly large, spherical platelets, in severely reduced numbers, and in prolonged bleeding times.
In addition to the platelet and megakaryocyte abnormalities, A/J-trac/trac mice had increased RBC fragility resulting in a mild hemolytic anemia with a regenerative response, evidenced by a doubling of the reticulocyte count. This RBC fragility is consistent with a reduction in the durability of the RBC membrane. There was also a 50% reduction in the leukocyte count due mostly to decreased numbers of lymphocytes. We identified other, nonhematogenous abnormalities including cardiomyopathy and infertility that will be the subjects of separate manuscripts (T.H.C. and L.D.S., manuscript in preparation).
Initial breeding experiments showed that both A/J-trac/trac males and females were infertile. The female infertility is not due to a germ cell defect since engraftment of ovaries from trac/trac females to immunodeficient recipients followed by mating to A/J +/+ males produced A/J +/trac mice. Results of intercrossing +/trac heterozygotes indicated that the trac mutation segregated as an autosomal recessive mutation. High-resolution mapping of the trac locus and sequencing of candidate genes revealed a G to A transition in the Abcg5 gene, and no DNA alterations in any of the other 3 genes within the candidate interval. This G to A substitution results in a premature stop codon and predicts a truncated protein that lacks the last 4 transmembrane domains of the wild-type protein, resulting in a defective ABCG5/ABCG8 heterodimer.
The ABCG5/ABCG8 heterodimer mediates the efflux of plant sterols and cholesterol from enterocytes into the intestinal lumen and the secretion of phytosterols from hepatocytes into the bile,31,34 thus limiting the accumulation of dietary phytosterols,29,30 which are common components of plant foods especially vegetable oils, seeds, nuts, and cereals.18 Mutations in either the human ABCG5 or ABCG8 genes are known to result in phytosterolemia.35
Phytosterols are structurally similar to cholesterol, differing only in the number of carbons or double bonds in the side chains.18 Cholesterol is one of the major lipid constituents of red blood cell membranes and functions in membrane permeability, fluidity, and rigidity.36,37 Significant alterations in the fluidity or durability of membranes may occur when phytosterols are incorporated.
Homozygosity for this spontaneous mutation in the Abcg5 gene results in pathologically high levels of plant sterol absorption on commonly used plant sterol–containing rodent diets. The measurement of blood levels of phytosterols in trac/trac mice showed an approximately 130-fold increase in free and approximately 60-fold increase in esterified sitosterol as well as significant elevations of free and esterified brassicasterol, campesterol, and sigmasterol. Although hypercholesterolemia is a feature of sitosterolemia in humans, there was no effect of the trac mutation on levels of free cholesterol, and levels of esterified cholesterol were decreased to approximately one half those found in plasma from littermate normal +/? controls. To confirm the link between phytosterolemia and abnormal thrombopoiesis, normal fetal megakaryocytes were cultured in normal and phytosterol-rich environments. Results showed a 63% reduction in the number of proplatelet-producing megakaryocytes when cultured in the presence of 5% A/J-trac/trac serum compared with culture in 5% A/J +/trac serum.
To corroborate the causative nature of the Abcg5 gene in trac/trac mice, we showed that the thrombocytopenia could be rescued by the human ABCG5/ABCG8 transgenes. We also showed that mice homozygous for the Abcg5/Abcg8 targeted mutation developed macrothrombocytopenia secondary to phytosterolemia. Recently, Kruit et al38 reported that mice homozygous for an Abcg5 targeted mutation develop macrothrombocytopenia accompanied by sitosterolemia. Treatment with ezetimibe to inhibit sterol absorption decreased sitosterol levels and reversed the macrothrombocytopenia. Our laboratory has found that providing trac/trac mice with a phytosterol-free diet also normalized platelet levels, and rescued other pathologic changes associated with phytosterolemia in these mice (T.H.C. and L.D.S., manuscript in preparation).
There were several differences between the findings in the Abcg5 targeted mutation studied by Kruit et al, and our findings in the spontaneous trac mutation. They reported an absence of RBC fragility in the Abcg5 knockout mice. We found that in the phytosterolemia of A/J-trac/trac mice, as in human phytosterolemia,35,39 there is red blood cell fragility and low-level hemolysis. Kruit et al also reported no change in megakaryocyte ploidy, whereas we found that there was a decrease in the polyploidy in trac/trac mice. In the Abcg5 targeted mutant mouse they did not find abnormalities in leukocyte populations, whereas we found a significant decrease in lymphocyte numbers in trac/trac mice. The cardiomyopathy and the spermatic abiotrophy that are prominent features in this spontaneous trac mutation were not reported in their targeted mutation. These differences could be due in part to strain background effects.
Although much is known about the role of ABCG5 as a heterodimeric partner in the uptake of plant sterols and cholesterol, the understanding of mechanisms by which these plant sterols interfere with development of membranes that depend on cholesterol and cholesterol metabolism is incomplete. It seems likely that mechanisms to exclude plant sterols from mammalian metabolism evolved because, although structurally very similar to cholesterol, there appear to be inherent disadvantages in the incorporation of these stoichemically different molecules into various membranes. The spontaneous trac mutation provides a model to extend investigations of mechanisms by which plant sterols interfere with megakaryocytopoiesis and the formation of platelets, red blood cells, cardiomyocytes, and other affected cells. Ongoing studies will identify targets for therapeutic intervention in the treatment of macrothrombocytopenia due to phytosterolemia.
Presented in part in abstract form at the 47th annual meeting of the American Society of Hematology, Atlanta, Georgia, December 10-13, 2005.40
The publication costs of this article were defrayed in part by page charge payment. Therefore, and solely to indicate this fact, this article is hereby marked “advertisement” in accordance with 18 USC section 1734.
Acknowledgments
We gratefully acknowledge Nick Cowan (New York University) for providing anti–β1-tubulin antibody, and Chlöe Bulinski for the kind gift of pAb SUP GLU. We thank David Serreze and Luanne Peters for critical review of the manuscript.
This work was supported by National Institutes of Health (NIH) grants (T32) RR-070 68-07TC (T.H.C.); HL-077642 (L.D.S.); and HL-68130 (J.E.I.); and NIH Cancer Core Grant CA-34196 to The Jackson Laboratory.
National Institutes of Health
Authorship
Contribution: P.L. discovered the mutant mouse; P.L. and B.H. investigated the inheritance; T.H.C., B.L.L., L.R.D., L.M.B., B.G., U.C., J.T., H.W., J.N.T., and L.D.S. performed the experiments; R.T.B. and O.F. carried out the histopathologic studies; T.H.C., B.L.L., L.M.B., J.N.T., J.E.I., K.R.J., and L.D.S. analyzed data and results; T.H.C., J.E.I., K.R.J., and L.D.S. designed the research; and T.H.C. and L.D.S. wrote the paper.
Conflict-of-interest disclosure: The authors declare no competing financial interests.
Correspondence: Leonard D. Shultz, The Jackson Laboratory, 600 Main St, Bar Harbor, ME; e-mail: lenny.shultz@jax.org.